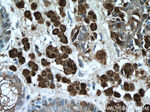
S100 beta Antibody in Immunohistochemistry (Paraffin) (IHC (P))
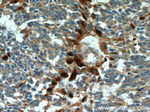
S100 beta Antibody in Immunohistochemistry (Paraffin) (IHC (P))

Search
Proteintech
S100 beta Polyclonal Antibody
{{$productOrderCtrl.translations['antibody.pdp.commerceCard.promotion.promotions']}}
{{$productOrderCtrl.translations['antibody.pdp.commerceCard.promotion.viewpromo']}}
{{$productOrderCtrl.translations['antibody.pdp.commerceCard.promotion.promocode']}}: {{promo.promoCode}} {{promo.promoTitle}} {{promo.promoDescription}}. {{$productOrderCtrl.translations['antibody.pdp.commerceCard.promotion.learnmore']}}
图: 1 / 17
S100 beta Antibody (15146-1-AP) in ICC/IF

产品信息
15146-1-AP
种属反应
已发表种属
宿主/亚型
分类
类型
抗原
偶联物
形式
浓度
规格
纯化类型
保存液
内含物
保存条件
运输条件
产品详细信息
Immunogen sequence: MSELEKAMV ALIDVFHQYS GREGDKHKLK KSELKELINN ELSHFLEEIK EQEVVDKVME TLDNDGDGEC DFQEFMAFVA MVTTACHEFF EHE (1-92 aa encoded by BC001766)
靶标信息
S100B is a member of the S100 family of proteins containing 2 EF-hand calcium-binding motifs. S100 proteins are localized in the cytoplasm and/or nucleus of a wide range of cells and are involved in the regulation of a number of cellular processes such as cell cycle progression and differentiation. S100B may function in neurite extension, proliferation of melanoma cells, stimulation of Ca2+ fluxes, inhibition of PKC-mediated phosphorylation, astrocytosis and axonal proliferation, and inhibition of microtubule assembly. Chromosomal rearrangements and altered expression of this gene have been implicated in several diseases, including Alzheimer's disease, Down's syndrome, epilepsy, amyotrophic lateral sclerosis, melanoma, and type I diabetes.
仅用于科研。不用于诊断过程。未经明确授权不得转售。
生物信息学
蛋白别名: Protein S100-B; S-100 calcium-binding protein, beta chain; S-100 protein beta chain; S-100 protein subunit beta; S100 calcium binding protein beta (neural); S100 calcium-binding protein B; S100 calcium-binding protein beta (neural); S100 calcium-binding protein, beta (neural); S100 protein beta chain; S100 protein, beta polypeptide, neural; S100B
基因别名: AI850290; Bpb; NEF; S100; S100-B; S100B; S100beta; S100P
UniProt ID: (Human) P04271, (Mouse) P50114, (Rat) P04631
Entrez Gene ID: (Human) 6285, (Mouse) 20203, (Rat) 25742




